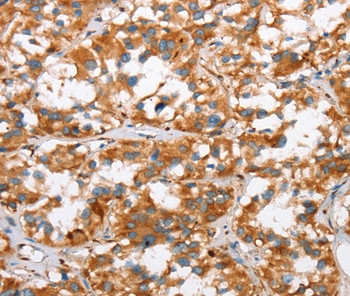
SLC4A1 Antibody in Immunohistochemistry (Paraffin) (IHC (P))

Search
Invitrogen
SLC4A1 Polyclonal Antibody
{{$productOrderCtrl.translations['antibody.pdp.commerceCard.promotion.promotions']}}
{{$productOrderCtrl.translations['antibody.pdp.commerceCard.promotion.viewpromo']}}
{{$productOrderCtrl.translations['antibody.pdp.commerceCard.promotion.promocode']}}: {{promo.promoCode}} {{promo.promoTitle}} {{promo.promoDescription}}. {{$productOrderCtrl.translations['antibody.pdp.commerceCard.promotion.learnmore']}}


Please note: We are reviewing Western blot images included in the antibody testing data in our catalog, including those provided by third parties. Unless expressly labeled or annotated as “raw-unedited”, Western blot images included in the antibody testing data in our catalog may have been edited, optimized or otherwise adjusted for presentation.
产品信息
PA5-50630
种属反应
宿主/亚型
分类
类型
抗原
偶联物
形式
浓度
规格
纯化类型
保存液
内含物
保存条件
运输条件
RRID
产品详细信息
The antibody detects endogenous levels of total SLC4A1 protein.
靶标信息
The Band 3 protein is the most abundant integral protein of human erythrocyte membranes and functions as the major anion transporter polypeptide of erythrocytes. Band 3 is a 90-100 kDa protein, its microheterogeneity is ascribed mainly to the structural heterogeneity of the carbohydrate moiety. The C-terminal portion of the molecule spans the membrane several times, and is responsible for anion transport. The N-terminal portion, comprising almost half of the polypeptide chain of Band 3, is located inside the red cell and interacts with cytoskeletal and cytoplasmic proteins such as ankyrin.
仅用于科研。不用于诊断过程。未经明确授权不得转售。
篇参考文献 (0)
生物信息学
蛋白别名: AE 1; Anion exchange protein 1; Band 3 anion transport protein; CAMP; CD233; MGC116750; MGC116753; MGC126619; MGC126623; Solute carrier family 4 member 1; ZNF828
基因别名: AE1; DI; EPB3; SLC4A1
Entrez Gene ID: (Human) 6521